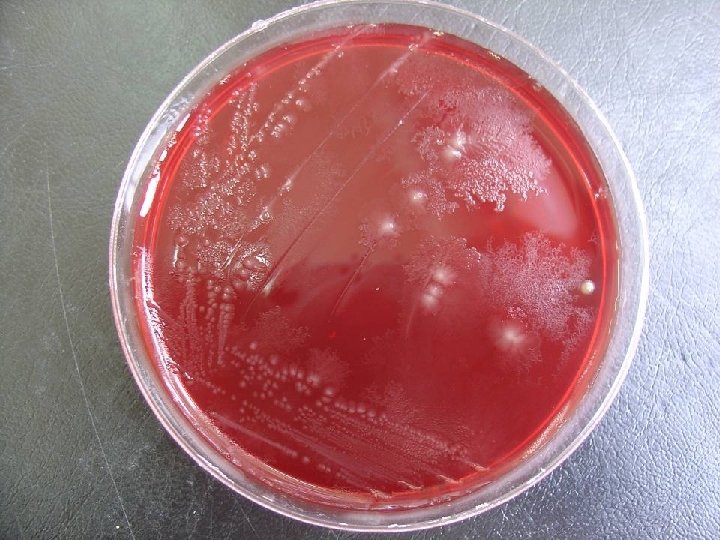
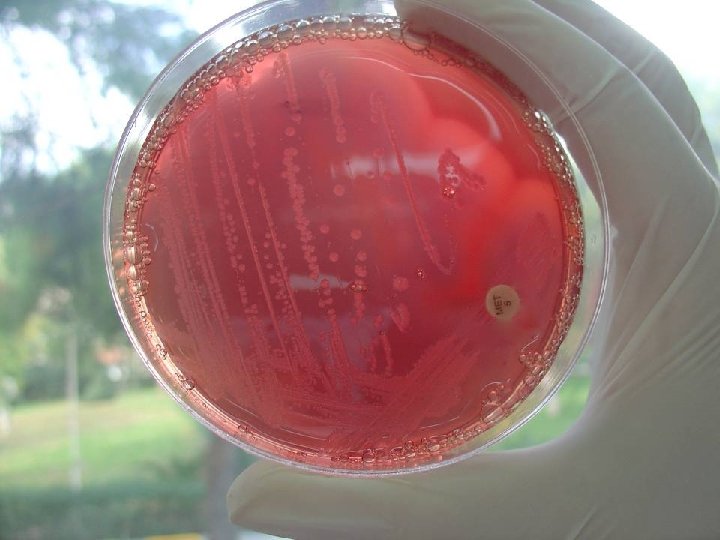
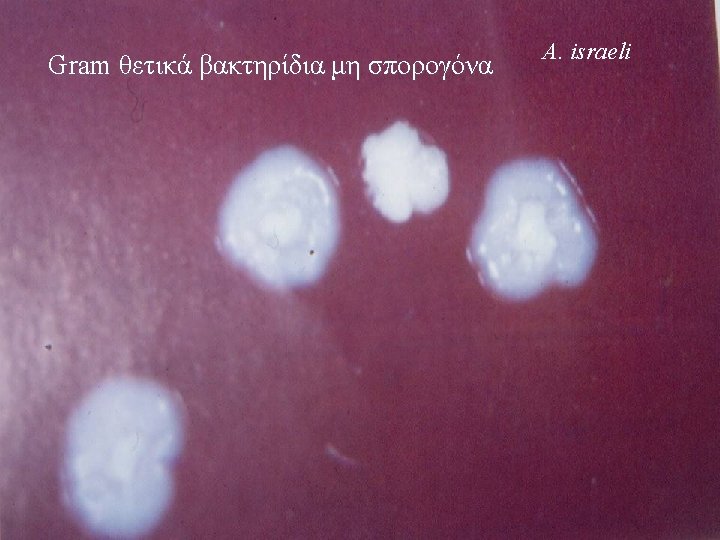
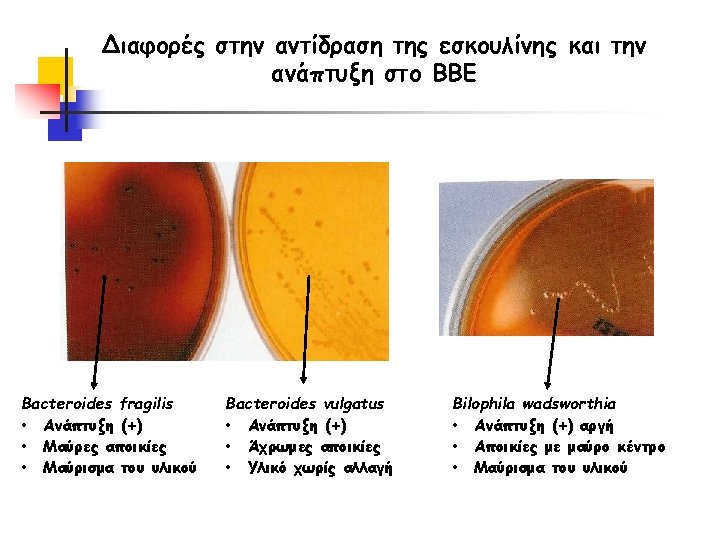
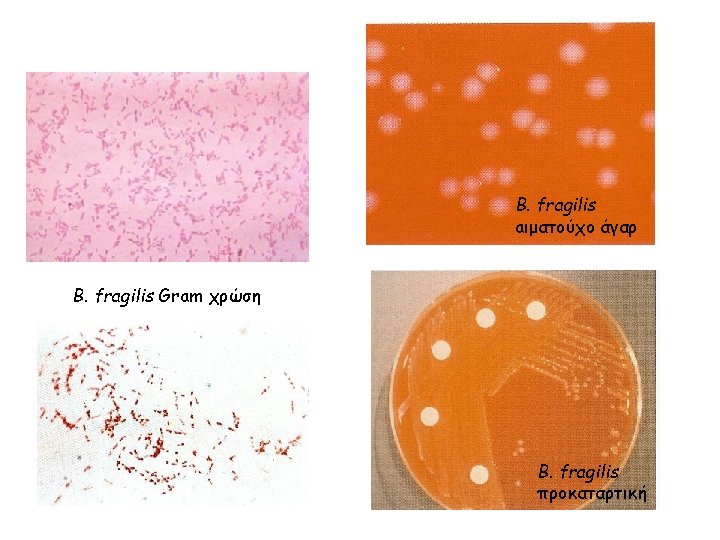
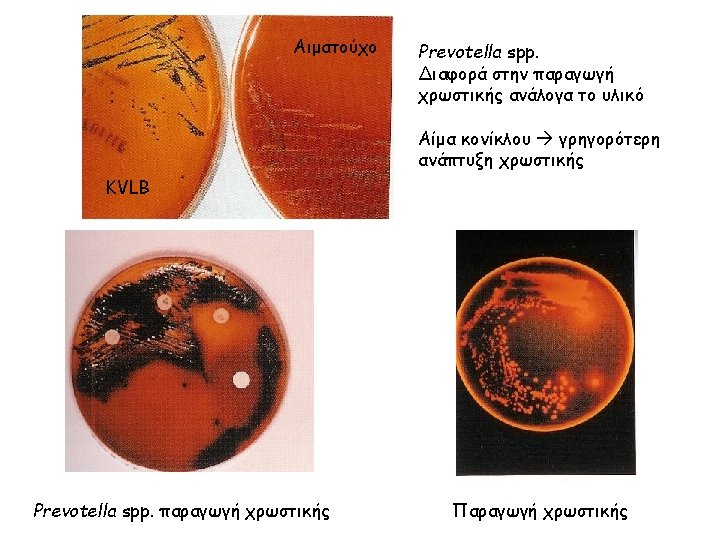

GRAM A v Gram Clostridium sp v Gram

- Slides: 91
GRAM ΘΕΤΙΚΑ ΑΝΑΕΡΟΒΙA v Gram θετικά βακτηρίδια σπορογόνα (Clostridium sp) v Gram θετικοί αναερόβιοι κόκκοι Peptostreptococcus sp P. anaerobius Parvimonas sp P. micra Finegoldia sp F. magna Peptoniphillus sp Pn. asaccharolyticus, Pn. indolicus, Pn. harei, Pn. lacrimalis, Pn. ivorii Anaerococcus sp An. prevotii, An. Tetradius, An. hydrogenalis, An. octavius An. lactolyticus, An. vaginalis Peptocoocus sp P. niger Atopobium sp A. parvula Coprococcus sp, Rominococcus sp Sarcina sp , Gallicola sp Gallicilo bamesae v. Gram θετικά βακτηρίδια μη σπορογόνα (Actimomyces sp, Propionibacterium sp, Lactobacillus sp, Bifidobacterium sp, Eubacterium sp )
Lactobacillus sp
Θρεπτικά υλικά για αναερόβια q Brucella blood agar εμπλουτισμένο με αιμίνη και βιταμίνη Κ 1 q Phenyl ethyl alcohol blood agar (PEA) q kanamycin-vancomycin laked blood agar (KVLB) q Bacteroides bile-esculin agar (BBE) q Thioglycolate broth εμπλουτισμένο με βιταμίνη K 1 και αιμίνη
C. novyi
C. difficile
C. septicum
C. perfringens
C. difficile
C. difficile
C. sporogenes
C. novyi
C. tetani
C. septicum
Λεκιθινάση + C. perfringens
Λιπάση + C. sporogenes
Nagler test Αντιτοξίνη C. perfrringens
Προκαταρκτική ταυτοποίηση κλωστηριδίων Λεκιθινάση + - Λιπάση - C. bifermenntas C. novyi Λιπάση + C. sporogenes - + Closridium sp C. sordelli C. barati C. limosum C. perfringens C. bifermenntas C. sordelli + C. sordelli Ουρεάση C. bifermenntas C. barati C. limosum C. perfringens + Ινδόλ η Ζελατίνη C. limosum C. perfringens - + C. barati
ΕΝΖΥΜΑΤΙΚΕΣ ΤΑΥΤΟΠΟΙΗΤΙΚΕΣ ΔΟΚΙΜΑΣΙΕΣ Ένζυμα Θετικό αποτέλεσμα Βακτήρια Glutamic acid decarboxylase amine (μπλε χρώμα) C. sordelii (+) C. bifermentans (-) L-proline β-naphythylamine aminopeptedas + cinnamaldehyde e ( ροζ-πορφυρό χρώμα) C. difficile C. innocuum (+) (-) α-Glucosidase μπλε φθορισμός (με UV 360 nm) 4 -methylumbelliferone C. septicum (+) C. sporogenes (-) Αλκαλική φωσφατάση 4 - nitrophenol Κίτρινο χρώμα An. hydrogenalis (+) An. accacharolyticus (-)
ΤΑΥΤΟΠΟΙΗΣΗ ΑΝΑΕΡΟΒΙΩΝ GRAM ΘΕΤΙΚΩΝ ΚΟΚΚΩΝ E Δίσκοι SPS A Peptostreptococcus anaerobius + Ουρεάση An. prevotii An. terradius + An. prevotii αγαλακτοσιδάση Ινδόλη - + - Pn. asaccharolyticus Micromonas micros <0, 6 An. hydrogenalis μm Αλκαλική Finegoldia magna > 0, 6 + φωσφατάση μm ή ζύμωση γλυκόζης An. tetradius An. hydrogenalis -- Pn. αsaccharolyticus
P. anaerobius
A. israeli
A. odondolyticus
Propionibacterium acnes
Ερώτηση 2η Gram (+) αναερόβιος κόκκος, ευαίσθητος στη Metronidazole με ζώνη αναστολής στο SPS >= 12 mm είναι: 1. Micromonas micros 2. Pertosrteptococcus anaerobius 3. Finegoldia magna 4. Όλα τα ανωτέρω
Gram-αρνητικά αναερόβια Αναερόβια Gram-αρνητικά βακτήρια ακίνητα Bacteroides spp. (fragilis group και non-fragilis), Prevotella spp. , Porphyromonas spp. , Fusobacterium spp. Αναερόβια Gram-αρνητικά βακτήρια κινητά Butyrivibrio, Succinivibrio, Campylobacter rectus, Selemonas, Anaerobiospirillum Αναερόβιοι Gram-αρνητικοί κόκκοι Veillonella spp.
Δισκία ειδικής περιεκτικότητας Van Kan Col Bacteroides fragilis group Α Α Α Bacteroides ureolyticus A E E Prevotella spp. A A Α/Ε Fusobacterium spp. A E E Porphyromonas spp. E A A Veillonella spp. A E E
Συνοπτική ταυτοποίηση Gram-αρνητικών Wadsworth – KTL Anaerobic Bacteriology Manual, 2004
Χαρακτηριστικά των ανθεκτικών στην χολή Bacteroides spp. (B. fragilis group και B. splanchnicus) Wadsworth – KTL Anaerobic Bacteriology Manual, 2004
Ταυτοποίηση σε επίπεδο είδους των ανθεκτικών στην χολή Bacteroides spp. (B. fragilis group και B. splanchnicus) Ινδόλη (+) Ινδόλη (-) Wadsworth – KTL Anaerobic Bacteriology Manual, 2004
Ανθεκτικά στην χολή Gram-αρνητικά Είδος Kan Col Van Ind Nit Urea B. fragilis R R R - - - Bilophila R S R - + + Sutterella R S R - + - Tissierella R R R - ± - F. varium S S R ± - -
Συνοπτική ταυτοποίηση Gram-αρνητικών Wadsworth – KTL Anaerobic Bacteriology Manual, 2004
Χαρακτηριστικά των χρωμογόνων Gram-αρνητικών στελεχών (Prevotella και Porphyromonas spp) Wadsworth – KTL Anaerobic Bacteriology Manual, 2004
Ταυτοποίηση σε επίπεδο είδους των χρωμογόνων Gramαρνητικών στελεχών (Prevotella και Porphyromonas spp) Ασακχαρολυτικά Porphyromonas spp. Σακχαρολυτικά Prevotella spp. Wadsworth – KTL Anaerobic Bacteriology Manual, 2004
Χαρακτηριστικά και ταυτοποίηση σε επίπεδο είδους των στελεχών Fusobacterium spp Λιπάση (-), μη αιμολυτικά στελέχη F. necrophorum F. pseudonecrophorum F. varium Wadsworth – KTL Anaerobic Bacteriology Manual, 2004
Fusobacterium spp. Είδος Ινδόλη Λιπάση Εσκουλίνη Χολή ONPG F. nucleatum + - - S - F. necrophorum + + - S - F. varium + - - R - F. mortiferum - - ± R +
F. nucleatum subsp. nucleatum F. nucleatum subsp. fusiforme F. nucleatum subsp. polymorphum F. necrophorum
F. nucleatum Gram χρώση F. necrophorum Gram χρώση F. mortiferum Gram χρώση